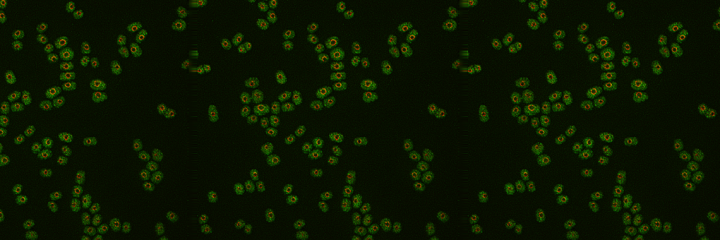

In the brain, dopamine helps regulate reward and body movement. As part of the reward pathway, dopamine is produced by neurons in the ventral tegmental area (VTA) and released in the nucleus accumbens and the prefrontal cortex, leading to the feeling of pleasure. Dopamine’s role in motor functions is linked to a separate pathway: first dopamine is produced in the substantia nigra and then it’s released in the striatum. While dopamine plays the same function in each case, malfunctions in the different pathways can cause vastly different diseases such as Parkinson’s and potentially schizophrenia.